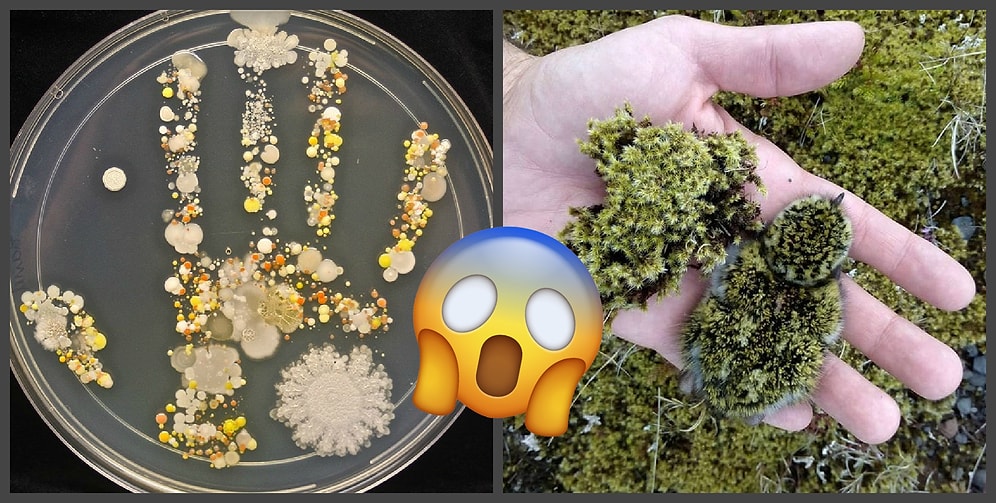
Потрясающие фото со всего мира, которые восхищают, шокируют и умиляют одновременно

Увидев эти снимки, вы не поверите, что это части одного фото
Порой, фотографируя, человек даже не осознает, что делает уникальный снимок. Ведь случайно в кадр могут попасть самые интересные детали, которые сложно запечатлеть в обычное время. Мы подобрали для вас фотографии, в реалистичность которых трудно поверить, потому что на одном снимке словно запечатлены два разных мира.